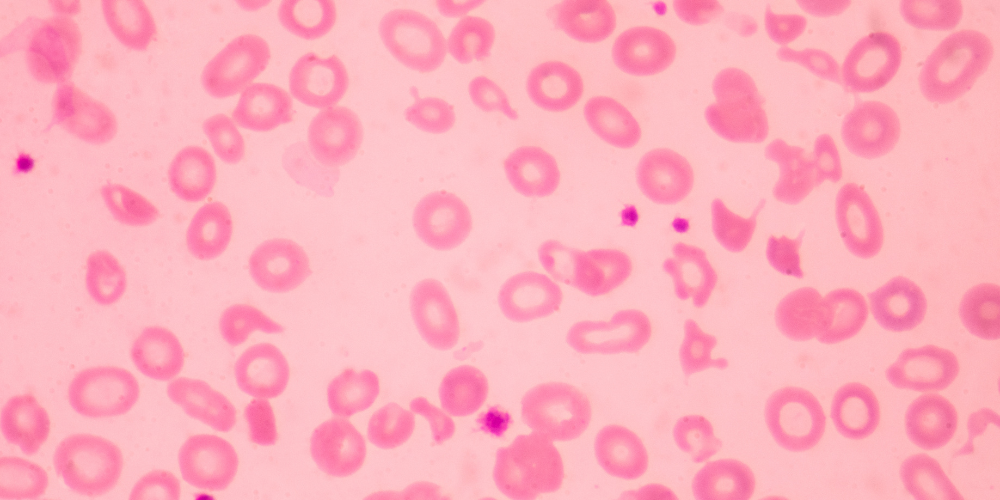

থ্যালাসেমিয়া রোগের কারণ ও লক্ষণ
থ্যালাসেমিয়া হলো একটি জেনেটিক বা জন্মগত রক্তের রোগ, যা রক্তে হিমোগ্লোবিন উৎপাদন প্রক্রিয়ায় সমস্যা সৃষ্টি করে। হিমোগ্লোবিন রক্তের মূল উপাদান, যা শরীরের কোষে অক্সিজেন পৌঁছে দেয়। থ্যালাসেমিয়ার কারণে শরীর পর্যাপ্ত হিমোগ্লোবিন তৈরি করতে পারে না, ফলে রক্তশূন্যতা বা অ্যানিমিয়া দেখা দেয়। এই রোগ শিশুর জন্মের সময় থেকেই প্রভাব ফেলতে পারে এবং প্রাপ্তবয়স্কদের ক্ষেত্রেও এর প্রভাব দীর্ঘস্থায়ী হয়।
বাংলাদেশে থ্যালাসেমিয়া একটি গুরুত্বপূর্ণ জনস্বাস্থ্য সমস্যা। বিশেষ করে যেখানে জেনেটিক ক্যারিয়ার বহনকারী দম্পতির মধ্যে বিবাহ বা সন্তান জন্মায়, সেখানে এই রোগের ঝুঁকি বেশি। পরিবার এবং সমাজে সচেতনতা না থাকলে রোগের জটিলতা দ্রুত বৃদ্ধি পায়। থ্যালাসেমিয়া শুধু শারীরিক সমস্যাই সৃষ্টি করে না, এটি মানসিক ও সামাজিক জীবনেও গভীর প্রভাব ফেলে।
রক্তের হিমোগ্লোবিন পর্যাপ্ত না থাকলে শিশুর শারীরিক বৃদ্ধি ধীর হয়। হাড়ের গঠন, মুখমণ্ডল এবং দাঁতের অবস্থার ওপর প্রভাব পড়ে। প্রাপ্তবয়স্কদের ক্ষেত্রে ক্লান্তি, দুর্বলতা, হৃদরোগ এবং অন্যান্য জটিলতা দেখা দিতে পারে। রোগী দৈনন্দিন কাজ, পড়াশোনা এবং সামাজিক কর্মকাণ্ডে অংশ নিতে অনেক সময় অক্ষম হয়।
থ্যালাসেমিয়ার ফলে শরীরের প্রতিরোধ ক্ষমতা দুর্বল হয়। সংক্রমণের ঝুঁকি বৃদ্ধি পায়, যা শিশুর বৃদ্ধি ও স্বাভাবিক জীবনে বাধা সৃষ্টি করে। রক্তের সমস্যা দীর্ঘমেয়াদে লিভার, প্লীহা এবং কিডনির কার্যক্ষমতাকেও প্রভাবিত করে। তাই রোগীকে নিয়মিত ডাক্তারি পরামর্শ, রক্ত পরীক্ষা এবং প্রয়োজনীয় চিকিৎসা নিতে হবে।
বাংলাদেশে এই রোগের সম্পর্কে সচেতনতা বাড়ানো জরুরি। পরিবার, স্কুল এবং সমাজকে রোগীকে সমর্থন করতে হবে। শিশুর মানসিক এবং সামাজিক বিকাশ নিশ্চিত করতে নিয়মিত মনিটরিং প্রয়োজন। প্রাপ্তবয়স্ক রোগীরা সচেতন থাকলে পেশাগত জীবন এবং পারিবারিক দায়িত্বও পালন করতে সক্ষম হয়।
থ্যালাসেমিয়ার চিকিৎসা পুরোপুরি নিরাময়যোগ্য না হলেও নিয়মিত চিকিৎসা এবং জীবনধারার সচেতনতা রোগীকে স্বাভাবিক জীবনযাপন করতে সহায়তা করে। চিকিৎসা ছাড়া রোগীর শারীরিক সমস্যা, মানসিক চাপ এবং সামাজিক জীবনে অংশগ্রহণের সীমাবদ্ধতা বৃদ্ধি পায়। তাই চিকিৎসা, পুষ্টিকর খাদ্য এবং মানসিক সহায়তা একসাথে থাকা অপরিহার্য।
শিশুদের ক্ষেত্রে বিশেষ যত্ন এবং পরিবারের সহযোগিতা তাদের শারীরিক ও মানসিক বিকাশের জন্য গুরুত্বপূর্ণ। প্রাপ্তবয়স্ক রোগীরা সচেতন হলে জীবনযাত্রার মান উন্নত করতে পারে। থ্যালাসেমিয়ার রোগীরা যদি নিয়মিত চিকিৎসা গ্রহণ করে, রোগের জটিলতা কমাতে সক্ষম হয় এবং দৈনন্দিন জীবন প্রায় স্বাভাবিকভাবে চালাতে পারে।
এই রোগের প্রতি সচেতনতা বৃদ্ধি এবং পরিবারের সহায়তা ছাড়া রোগী মানসিক চাপ এবং হতাশার শিকার হতে পারে। তাই থ্যালাসেমিয়া সম্পর্কে শিক্ষিত হওয়া, নিয়মিত পরীক্ষা করা এবং চিকিৎসা নেওয়া অপরিহার্য। রোগীকে শারীরিক ও মানসিকভাবে সুস্থ রাখতে পরিবার, স্কুল এবং সমাজের ভূমিকা খুব গুরুত্বপূর্ণ।
বাংলাদেশে থ্যালাসেমিয়ার প্রতি সচেতনতা বাড়ানো, রোগের ঝুঁকি কমানো এবং নিয়মিত চিকিৎসা গ্রহণ নিশ্চিত করা প্রয়োজন। শিশু ও প্রাপ্তবয়স্ক উভয় ক্ষেত্রেই রোগীর মানসিক ও শারীরিক স্বাস্থ্যের উন্নতি সম্ভব। শারীরিক সমস্যা যেমন ক্লান্তি, দুর্বলতা এবং হাড়ের বিকৃতি নিয়ন্ত্রণে আনা যায়। মানসিক চাপ কমিয়ে রোগী সামাজিক ও শিক্ষাজীবনে অংশ নিতে সক্ষম হয়।
সুতরাং থ্যালাসেমিয়া একটি জটিল রোগ হলেও, সচেতনতা, চিকিৎসা এবং পরিবার-সমাজের সহায়তায় রোগী দীর্ঘমেয়াদি সুস্থ জীবনযাপন করতে পারে। নিয়মিত রক্ত পরীক্ষা, চিকিৎসা, পুষ্টিকর খাদ্য, পর্যাপ্ত বিশ্রাম এবং মানসিক সহায়তা একসাথে থাকলে রোগীর জীবনমান অনেক উন্নত করা সম্ভব।
থ্যালাসেমিয়া কি?

থ্যালাসেমিয়া হলো একধরনের জেনেটিক বা বংশগত রোগ, যা মূলত রক্তের লোহিত কণিকা তৈরির প্রক্রিয়াকে প্রভাবিত করে। স্বাভাবিক অবস্থায় আমাদের শরীর হিমোগ্লোবিন নামক একটি প্রোটিন তৈরি করে, যা অক্সিজেনকে সারা শরীরে পৌঁছে দেয়। কিন্তু থ্যালাসেমিয়ায় আক্রান্তদের শরীরে হিমোগ্লোবিন সঠিকভাবে তৈরি হয় না। এর ফলে রোগীরা খুব দ্রুত ক্লান্ত হয়ে পড়ে, দুর্বল হয়ে যায় এবং প্রায়ই রক্তশূন্যতায় ভোগে। বাংলাদেশে এ রোগের বাহক সংখ্যা অত্যন্ত বেশি। বিভিন্ন গবেষণায় দেখা গেছে, প্রায় ১২% মানুষ থ্যালাসেমিয়ার বাহক থ্যালাসেমিয়া ফাউন্ডেশন বাংলাদেশ। অর্থাৎ, দুইজন বাহক বিবাহ করলে তাদের সন্তান থ্যালাসেমিয়ায় আক্রান্ত হওয়ার ঝুঁকি অনেক বেশি। এ কারণে এ রোগকে শুধু চিকিৎসাজনিত সমস্যা নয়, বরং একটি সামাজিক ও জাতীয় সমস্যা হিসেবেও বিবেচনা করা হয়।
থ্যালাসেমিয়া রোগের কারণ ও লক্ষণ

থ্যালাসেমিয়ার মূল কারণ হলো জেনেটিক পরিবর্তন। অর্থাৎ, বাবা-মায়ের কাছ থেকে সন্তানের শরীরে ত্রুটিপূর্ণ জিন চলে আসে। যদি উভয় বাবা-মা বাহক হয়, তবে সন্তানের আক্রান্ত হওয়ার সম্ভাবনা বেড়ে যায়। এ রোগের লক্ষণগুলো ধীরে ধীরে প্রকাশ পায়।বিস্তারিত আলোচনা করা হলো –
১. রক্তশূন্যতা
থ্যালাসেমিয়ার সবচেয়ে সাধারণ লক্ষণ হলো রক্তশূন্যতা বা অ্যানিমিয়া। এই রোগে শরীর পর্যাপ্ত হিমোগ্লোবিন তৈরি করতে পারে না, ফলে রক্তে অক্সিজেনের ঘাটতি দেখা দেয়। শরীরের সমস্ত কোষ পর্যাপ্ত অক্সিজেন না পেয়ে দুর্বল হয়ে পড়ে। রোগীরা অল্প কাজ করেও ক্লান্ত হয়ে পড়ে। সকাল উঠার পরও শক্তির ঘাটতি অনুভব হয়। হাঁটাহাঁটি, দৌড়ঝাপ বা সিঁড়ি ওঠার মতো সাধারণ কাজও কষ্টকর হয়ে ওঠে। শিশুদের ক্ষেত্রে এটি পড়াশোনা এবং খেলাধুলায় প্রভাব ফেলে। অনেক সময় তারা ক্লাসে মনোযোগ দিতে পারে না। বৃদ্ধ বয়সের মানুষের ক্ষেত্রে হৃদপিণ্ডের উপর চাপ বৃদ্ধি পায়। দীর্ঘমেয়াদে হৃৎপিণ্ড দুর্বল হতে পারে। লিভার এবং প্লীহাও প্রভাবিত হয়। রক্তশূন্যতা থাকলে চোখে হালকা ফ্যাকাশে ভাব দেখা যায়। মুখের রঙ ফ্যাকাশে হয়ে যায়। নখ দুর্বল হয়ে ভেঙে যায়। গলা ব্যথা বা শ্বাসকষ্ট হতে পারে। খিদে কমে যায়। ওজন কমে যেতে পারে। ত্বকও শুকনো ও ফ্যাকাশে হতে পারে। ক্লান্তি ছাড়া শরীরে দুর্বলতার অনুভূতি বারবার ঘটে। শিশুদের বৃদ্ধি ব্যাহত হয়। শারীরিক কর্মকাণ্ডে অংশগ্রহণ কমে যায়। হঠাৎ মাথা ঘোরা বা অজ্ঞান হওয়ার ঘটনা ঘটতে পারে। রক্তশূন্যতা ধীরে ধীরে অন্যান্য অঙ্গপ্রত্যঙ্গকে দুর্বল করে। চিকিৎসা না পেলে এটি জীবন হুমকিসহ জটিলতা সৃষ্টি করে।
২. দুর্বলতা ও ক্লান্তি
থ্যালাসেমিয়ায় আক্রান্ত ব্যক্তিদের সবচেয়ে সাধারণ এবং চোখে পড়ার মতো লক্ষণ হলো দীর্ঘস্থায়ী দুর্বলতা এবং ক্লান্তি। এটি এমন একটি সমস্যা যা রোগীর দৈনন্দিন জীবনকে গভীরভাবে প্রভাবিত করে। সকাল উঠার পরও শরীর ভারী এবং দুর্বল মনে হয়। ছোট ছোট কাজ যেমন হাঁটাহাঁটি, সিঁড়ি ওঠা বা সামান্য শারীরিক শ্রম করতেও শরীরের শক্তি দ্রুত শেষ হয়ে যায়। শিশুদের ক্ষেত্রে এটি স্কুলের কার্যক্রম, খেলাধুলা এবং অন্যান্য শারীরিক ক্রিয়াকলাপকে প্রভাবিত করে। তারা সহজেই ক্লান্ত হয়ে পড়ে, অনেক সময় পুরো ক্লাস বা খেলার সময়ও অংশ নিতে অক্ষম হয়।
প্রাপ্তবয়স্কদের জন্যও এটি সমস্যা তৈরি করে। অফিসের কাজ, দৈনন্দিন বাড়ির কাজ, বাজারে যাওয়া বা সামাজিক কার্যক্রমে অংশ নেওয়া কঠিন হয়ে যায়। শরীরের ক্লান্তি এবং দুর্বলতা মানসিক চাপও তৈরি করে। অনেক রোগী হালকা কাজ করেও অতিরিক্ত শ্বাসকষ্ট, মাথা ঘোরা বা চোখে ঝাপসা ভাব অনুভব করে। এছাড়া হাত-পা ঠান্ডা, গা ব্যথা এবং সামান্য হাঁটাচলাতেও দুর্বলতা দেখা দেয়।
দীর্ঘমেয়াদে, নিয়মিত ক্লান্তি রোগীর পেশি দুর্বল করে এবং শরীরের অন্যান্য অঙ্গপ্রত্যঙ্গের কার্যক্ষমতা হ্রাস পায়। রোগীরা তাদের দৈনন্দিন কাজ করতে হিমশিম খায়। পড়াশোনা ও অফিসের কাজের ক্ষেত্রে মনোযোগ দিতে পারে না। খাদ্য গ্রহণে আগ্রহ কমে যায়, যার ফলে পুষ্টির ঘাটতি দেখা দেয় এবং ক্লান্তি আরও বৃদ্ধি পায়। নিয়মিত রক্ত সঞ্চালন ও চিকিৎসা ছাড়া এই সমস্যা ক্রমশ বাড়তে থাকে।
ক্লান্তির কারণে রোগীরা সামাজিক অনুষ্ঠানে অংশ নিতে অনেক সময় অনীহা দেখায়। এতে মানসিক চাপ এবং হতাশা বৃদ্ধি পায়। শিশুদের ক্ষেত্রে আত্মবিশ্বাস কমে যায় এবং তারা সহপাঠীদের তুলনায় পিছিয়ে পড়ে। প্রাপ্তবয়স্করা কাজের জন্য পর্যাপ্ত শক্তি রাখতে পারে না, যা পারিবারিক ও সামাজিক জীবনে নেতিবাচক প্রভাব ফেলে।
অনেক সময় রোগীরা তাদের দুর্বলতা অন্যের কাছে লুকাতে চেষ্টা করে, কিন্তু শারীরিক সীমাবদ্ধতা স্পষ্ট হয়ে যায়। নিয়মিত চিকিৎসা ও রক্ত সঞ্চালন ছাড়া তাদের জীবনযাত্রা স্বাভাবিক রাখা কঠিন হয়ে যায়। আয়রন কেলেশন থেরাপি এবং পর্যাপ্ত পুষ্টি গ্রহণে কিছুটা স্বস্তি পাওয়া যায়। তবে এটি সম্পূর্ণ সমাধান নয়।
শিশুদের ক্ষেত্রে ক্লান্তি পড়াশোনা, খেলাধুলা এবং বন্ধুত্বপূর্ণ সম্পর্কের উপর প্রভাব ফেলে। প্রাপ্তবয়স্কদের ক্ষেত্রে পেশাগত দক্ষতা হ্রাস পায় এবং জীবনযাপন জটিল হয়ে ওঠে। রোগীর শরীরের দুর্বলতা দীর্ঘমেয়াদে হৃৎপিণ্ড, লিভার ও কিডনির কার্যক্ষমতাকেও প্রভাবিত করে। নিয়মিত ডাক্তারি পরামর্শ, স্বাস্থ্যকর জীবনধারা এবং পর্যাপ্ত বিশ্রাম অত্যন্ত জরুরি।
শারীরিক ক্লান্তির সঙ্গে মানসিক ক্লান্তিও যুক্ত হয়। রোগীরা হতাশা, বিষণ্নতা এবং আত্মবিশ্বাসের অভাব অনুভব করে। পরিবারের সমর্থন, মানসিক সহায়তা এবং সামাজিক সহযোগিতা ছাড়া তারা তাদের দৈনন্দিন কাজ সম্পাদন করতে কঠিন অনুভব করে। তাই থ্যালাসেমিয়ায় আক্রান্তদের জন্য শারীরিক ও মানসিক সহায়তা একসাথে প্রদান করা আবশ্যক।
৩. চামড়ার রঙ ফ্যাকাশে হওয়া
থ্যালাসেমিয়ায় আক্রান্ত ব্যক্তিদের আরেকটি স্পষ্ট লক্ষণ হলো চামড়ার রঙ ফ্যাকাশে বা হলদেটে হয়ে যাওয়া। এটি প্রধানত রক্তে হিমোগ্লোবিনের অভাবের কারণে ঘটে। হিমোগ্লোবিনের পর্যাপ্ত পরিমাণ না থাকায় শরীরের কোষগুলো পর্যাপ্ত অক্সিজেন পায় না, ফলে ত্বক হালকা ও ফ্যাকাশে দেখায়। মুখমণ্ডল, ঠোঁট, চোখের পাতা এবং নখের নিচের অংশে ফ্যাকাশে বা হলদে ভাব চোখে পড়ে। শিশুরা প্রায়শই এতে সবচেয়ে আগে লক্ষ্য করা যায়। প্রাপ্তবয়স্কদের ক্ষেত্রে চামড়ার ফ্যাকাশে ভাব সামাজিকভাবে প্রভাব ফেলে।
অনেক সময় মানুষ এটিকে অপুষ্টি বা অনিদ্রার ফল মনে করে। তবে মূল কারণ হলো রক্তের গঠনজনিত সমস্যা। ফ্যাকাশে ত্বক রোগীর শারীরিক দুর্বলতা এবং ক্লান্তির সঙ্গে যুক্ত থাকে। দীর্ঘ সময় ধরে ত্বক ফ্যাকাশে থাকলে এটি স্থায়ী হতে পারে। চোখের সাদা অংশেও হলদে ভাব দেখা যায়। প্রস্রাবের রঙ গাঢ় হতে পারে। ফ্যাকাশে ত্বক শিশুদের আত্মবিশ্বাস কমিয়ে দেয়। প্রাপ্তবয়স্কদের সামাজিক কর্মকাণ্ডে অংশগ্রহণে সমস্যা তৈরি করে।
ত্বকের ফ্যাকাশে ভাবের সঙ্গে জড়িত অন্যান্য লক্ষণ হলো চুল ঝরে যাওয়া, নখ ভাঙা, ঠোঁট ফাটলে দ্রুত সৃষ্টির কারণ। রোগী সহজেই ক্লান্ত হয়ে পড়ে। খাবারের প্রতি আগ্রহ কমে যায়, পুষ্টির ঘাটতি আরও বাড়ে। দীর্ঘমেয়াদে ত্বক শুকনো এবং ক্ষতিগ্রস্ত হতে পারে। নিয়মিত রক্ত সঞ্চালন, পুষ্টিকর খাবার এবং চিকিৎসা গ্রহণের মাধ্যমে কিছুটা স্বাভাবিক রঙ ফিরিয়ে আনা সম্ভব।
শিশুদের ক্ষেত্রে ফ্যাকাশে ত্বক তাদের খেলাধুলা ও স্কুলের কার্যক্রমে প্রভাব ফেলে। প্রাপ্তবয়স্কদের ক্ষেত্রে এটি আত্মবিশ্বাস কমিয়ে দেয়। মানসিক চাপ বৃদ্ধি পায়। পরিবার ও সামাজিক সহযোগিতা ছাড়া তাদের দৈনন্দিন জীবনযাপন কঠিন হয়। ত্বকের ফ্যাকাশে ভাবের সঙ্গে ক্লান্তি, দুর্বলতা, রক্তশূন্যতা সব মিলিয়ে রোগীর জীবনযাত্রাকে জটিল করে তোলে। তাই থ্যালাসেমিয়ার ক্ষেত্রে ত্বকের ফ্যাকাশে ভাবকে লক্ষ্য করে দ্রুত চিকিৎসা গ্রহণ করা জরুরি।
৪. শিশুর বৃদ্ধি ধীরগতি হওয়া
থ্যালাসেমিয়ায় আক্রান্ত শিশুরা প্রায়শই তাদের সহবয়সীদের তুলনায় ছোট ও কম ওজনে থাকে। হাড়ের বৃদ্ধি ধীর হয়, দাঁতের গঠন স্বাভাবিকভাবে বিকশিত হয় না। মানসিক বিকাশও প্রভাবিত হতে পারে। স্কুলে মনোযোগ কম থাকে, খেলাধুলায় অংশগ্রহণ সীমিত হয়। প্রতিরোধ ক্ষমতা কমে যাওয়ায় বারবার সংক্রমণ হয়। পুষ্টি সঠিক হলেও রক্তশূন্যতা বৃদ্ধির কারণে বৃদ্ধি ব্যাহত হয়।
হাড়ের বিকৃতি দেখা দেয়, মুখমণ্ডল চওড়া হয়, কপাল ও গালের হাড় উঁচু হয়ে যায়। দাঁতের সারি অপ্রাকৃতিকভাবে গড়ায়। শিশুরা সামাজিক ও মানসিকভাবে প্রভাবিত হয়। আত্মবিশ্বাস কমে যায়। তারা বন্ধুত্বপূর্ণ সম্পর্ক তৈরি করতে অস্বস্তি বোধ করে। খেলাধুলায় অংশ নেওয়া কমে যায়। পড়াশোনার ফলাফল খারাপ হতে পারে। চিকিৎসা এবং নিয়মিত রক্ত সঞ্চালন ছাড়া শিশুদের স্বাভাবিক বিকাশ সম্ভব নয়।
পুষ্টি, পর্যাপ্ত ঘুম এবং স্বাস্থ্যকর জীবনধারা নিশ্চিত করলেও হাড়ের বিকৃতি এবং বৃদ্ধি ব্যাহত হওয়া সমস্যা দীর্ঘমেয়াদে অব্যাহত থাকতে পারে। তাই থ্যালাসেমিয়ার শিশুদের বিশেষ যত্নের প্রয়োজন। প্রাপ্তবয়স্কদের অভিজ্ঞতা থেকে দেখা যায়, যারা শিশু অবস্থায় নিয়মিত চিকিৎসা পেয়েছে, তাদের শারীরিক বৃদ্ধি তুলনামূলকভাবে স্বাভাবিক হয়েছে। পরিবার এবং স্কুলের সহযোগিতা তাদের মানসিক স্বাস্থ্য রক্ষা করে।
৫. হাড়ের গঠন পরিবর্তন
থ্যালাসেমিয়ায় হাড়ের গঠন পরিবর্তিত হয়, বিশেষ করে মুখমণ্ডল, দাঁত এবং মাথার হাড়ে। কপাল চওড়া হয়, গাল উঁচু হয়ে যায়, দাঁতের সারি অপ্রাকৃতিকভাবে বিকৃত হয়। শিশুর চেহারার স্বাভাবিক আকৃতি পরিবর্তিত হয়। প্রাপ্তবয়স্কদের ক্ষেত্রে সামাজিকভাবে এই পরিবর্তন নেতিবাচক প্রভাব ফেলে।
হাড়ের পরিবর্তন মূলত অস্থিমজ্জার অতিরিক্ত কাজের কারণে ঘটে। হাড়ের বিকৃতি রোগীর আত্মবিশ্বাস কমিয়ে দেয়। দাঁতের সমস্যা দেখা দেয়, মুখমণ্ডলের আকৃতি অস্বাভাবিক হয়। এটি শারীরিক স্বাস্থ্যের পাশাপাশি মানসিক স্বাস্থ্যের উপরও প্রভাব ফেলে। শিশুরা সামাজিকভাবে আত্মমর্যাদা হারায়। প্রাপ্তবয়স্কদের ক্ষেত্রে চাকরি বা সামাজিক অনুষ্ঠানে অংশগ্রহণে সমস্যা হয়।
চিকিৎসা না করলে পরিস্থিতি আরও খারাপ হয়। নিয়মিত রক্ত সঞ্চালন, পুষ্টিকর খাদ্য এবং চিকিৎসা দ্বারা হাড়ের বিকৃতি কিছুটা নিয়ন্ত্রণ করা সম্ভব। মানসিক সহায়তা প্রদান রোগীর মানসিক স্বাস্থ্য রক্ষা করে
৬. সংক্রমণের ঝুঁকি
থ্যালাসেমিয়ায় আক্রান্ত ব্যক্তিদের রোগ প্রতিরোধ ক্ষমতা কমে যায়। এর ফলে তারা সহজেই সংক্রমণের শিকার হয়। সাধারণ সর্দি-কাশি থেকে শুরু করে নিউমোনিয়া, ডায়রিয়া এবং অন্যান্য সংক্রমণ বারবার হতে পারে। শিশুদের ক্ষেত্রে এটি বিশেষভাবে ঝুঁকিপূর্ণ, কারণ তাদের রোগ প্রতিরোধ ক্ষমতা প্রাপ্তবয়স্কদের তুলনায় কম থাকে। শিশুরা স্কুলে, খেলার মাঠে বা অন্যান্য সামাজিক কার্যক্রমে অংশ নিতে গিয়ে সংক্রমণ নিতে পারে।
প্রাপ্তবয়স্করা কাজের জায়গায় বা বাড়িতে সংক্রমণের ঝুঁকির মধ্যে থাকে। রক্ত সঞ্চালনের মাধ্যমে হেপাটাইটিস বি বা সি-এর মতো মারাত্মক ভাইরাসও শরীরে প্রবেশ করতে পারে। নিয়মিত সংক্রমণ ছাড়া শিশুদের বৃদ্ধি ব্যাহত হয়। বারবার সংক্রমণের কারণে ক্লান্তি আরও বৃদ্ধি পায়। রোগীর শরীর দুর্বল হয়ে পড়ে এবং দৈনন্দিন কাজ করা কঠিন হয়ে যায়।
সংক্রমণ নিয়ন্ত্রণে না আনলে এটি জীবনহুমকিসহ জটিলতা সৃষ্টি করে। তাই পরিচ্ছন্নতা বজায় রাখা, নিয়মিত হাত ধোয়া, টিকা নেওয়া এবং চিকিৎসকের পরামর্শ মেনে চলা অত্যন্ত গুরুত্বপূর্ণ। খাবার ও পানীয় নিরাপদভাবে গ্রহণ করতে হবে। সঠিক পুষ্টি এবং পর্যাপ্ত বিশ্রাম সংক্রমণ প্রতিরোধে সাহায্য করে। মানসিক চাপ কমিয়ে সঠিক যত্ন নিলে সংক্রমণের ঝুঁকি অনেকাংশে কমানো যায়।
শিশুদের ক্ষেত্রে সংক্রমণ তাদের পড়াশোনা ও খেলাধুলায় প্রভাব ফেলে। প্রাপ্তবয়স্কদের ক্ষেত্রে পেশাগত দক্ষতা হ্রাস পায়। পরিবারে রোগীর দেখাশোনা করা দরকার। সংক্রমণের কারণগুলো চিহ্নিত করে প্রতিরোধমূলক ব্যবস্থা গ্রহণ করা উচিত। চিকিৎসা ও পর্যবেক্ষণের মাধ্যমে সংক্রমণ নিয়ন্ত্রণে রাখা সম্ভব।
৭. প্লীহা ও লিভার বড় হয়ে যাওয়া
থ্যালাসেমিয়ায় অতিরিক্ত রক্ত ভাঙার কারণে প্লীহা এবং লিভার বড় হয়ে যায়। প্লীহা (স্প্লিন) অতিরিক্ত রক্ত ভাঙা এবং ধ্বংস করার চেষ্টা করে। এর ফলে পেট ফুলে যায় এবং রোগী অসুবিধা অনুভব করে। লিভারও বড় হয়, যার কারণে হেপাটোমেগালি দেখা দেয়।
প্লীহা বড় হওয়ার ফলে শরীরের রক্ত সঞ্চালনের চাপ বৃদ্ধি পায়। রোগীরা দুর্বল বোধ করে। পেট ফোলা ও অস্বস্তি দেখা দেয়। রোগীর রক্ত শোষণ এবং তৈরি প্রক্রিয়া ব্যাহত হয়। দীর্ঘমেয়াদে প্লীহা অপসারণের জন্য অস্ত্রোপচার প্রয়োজন হতে পারে। তবে অপারেশনের পরে সংক্রমণের ঝুঁকি বেড়ে যায়। লিভারের বড় হওয়া জন্ডিস, হেপাটাইটিস বা লিভার ফেইলিউরের ঝুঁকি বৃদ্ধি করে।
নিয়মিত চিকিৎসা ও রক্ত সঞ্চালন রোগীর জীবনমান রক্ষা করতে সাহায্য করে। পুষ্টিকর খাদ্য এবং পর্যাপ্ত বিশ্রাম প্রয়োজন। পরিবার এবং চিকিৎসকের সহায়তায় রোগী নিয়মিত মনিটরিং করা উচিত। প্লীহা ও লিভারের বড় হওয়া প্রাথমিকভাবে চোখে পড়ে না, তাই নিয়মিত পরীক্ষা জরুরি।
৮. হৃৎপিণ্ডের সমস্যা
থ্যালাসেমিয়ায় রক্তশূন্যতা ও শরীরে অতিরিক্ত আয়রন জমা হওয়ার কারণে হৃদপিণ্ড দুর্বল হয়ে পড়ে। হৃদযন্ত্রের কার্যক্ষমতা কমে যায় এবং হৃদস্পন্দন অনিয়মিত হতে পারে। দীর্ঘমেয়াদে এটি হার্ট ফেইলিউরের ঝুঁকি বাড়ায়। অনেক রোগীর হৃদযন্ত্র বড় হয়ে যায় এবং রক্ত সঠিকভাবে পাম্প করতে পারে না।
বয়স্ক এবং শিশু উভয় ক্ষেত্রেই হৃদরোগের ঝুঁকি থাকে। নিয়মিত রক্ত সঞ্চালন এবং কেলেশন থেরাপি সাহায্য করে অতিরিক্ত আয়রন বের করতে। হৃৎপিণ্ডের সমস্যা দীর্ঘমেয়াদে জীবনহুমকিসহ জটিলতা তৈরি করে। চিকিৎসা না পেলে শ্বাসকষ্ট, ক্লান্তি এবং দুর্বলতা আরও বৃদ্ধি পায়। নিয়মিত ডাক্তারের পরামর্শ নেওয়া জরুরি।
শিশুদের ক্ষেত্রে হৃৎপিণ্ড দুর্বল হওয়ার কারণে খেলাধুলায় অংশগ্রহণ কমে যায়। প্রাপ্তবয়স্কদের ক্ষেত্রে পেশাগত কার্যক্রম প্রভাবিত হয়। পরিবার এবং সামাজিক জীবনেও প্রভাব পড়ে। রোগীর মানসিক চাপ এবং হতাশা বৃদ্ধি পায়। তাই থ্যালাসেমিয়ায় হৃদরোগের ঝুঁকি কমাতে সচেতন থাকা প্রয়োজন।
৯. গাঢ় প্রস্রাব
থ্যালাসেমিয়ায় আক্রান্তদের প্রস্রাব প্রায়শই গাঢ় রঙ ধারণ করে। রক্ত ভাঙার ফলে হিমোগ্লোবিন ইউরিনে চলে যায় এবং প্রস্রাব গাঢ় হলুদ বা বাদামী রঙের হয়ে ওঠে। দীর্ঘমেয়াদে কিডনির কার্যক্ষমতা কমে যেতে পারে। অনেক সময় এটি অন্য রোগের সঙ্গে বিভ্রান্তি তৈরি করে।
গাঢ় প্রস্রাব দেখা দিলে রোগী এবং পরিবার সতর্ক হয়ে ওঠে। এটি কিডনি এবং লিভারের উপর অতিরিক্ত চাপ সৃষ্টি করে। নিয়মিত পরীক্ষা এবং চিকিৎসা ছাড়া সমস্যা বাড়তে থাকে। চিকিৎসকরা হিমোগ্লোবিনের মাত্রা পরীক্ষা করে সঠিক চিকিৎসা শুরু করেন। নিয়মিত পর্যবেক্ষণ রোগীর জীবনমান রক্ষা করে।
শিশুদের ক্ষেত্রে গাঢ় প্রস্রাব পড়াশোনা ও খেলাধুলায় প্রভাব ফেলতে পারে। প্রাপ্তবয়স্কদের ক্ষেত্রে দৈনন্দিন কাজ প্রভাবিত হয়। পরিবারের সহযোগিতা ও চিকিৎসা ছাড়া এটি জীবনযাত্রাকে জটিল করে তোলে। পুষ্টিকর খাদ্য, পর্যাপ্ত জলপান এবং চিকিৎসা গ্রহণ জরুরি।
১০. মানসিক প্রভাব
থ্যালাসেমিয়ার দীর্ঘমেয়াদি প্রভাব মানসিক স্বাস্থ্যেও পড়ে। রোগীরা হতাশা, হীনমন্যতা এবং আত্মবিশ্বাস কমে যাওয়ার মতো মানসিক সমস্যায় ভোগে। শিশুদের স্কুল, বন্ধু এবং সামাজিক কার্যক্রমে অংশ নেওয়া কঠিন হয়ে যায়। তারা আত্মমর্যাদা হারায় এবং একাকিত্ব অনুভব করে।
প্রাপ্তবয়স্কদের ক্ষেত্রে এটি পেশাগত ও পারিবারিক জীবনে প্রভাব ফেলে। সামাজিক অনুষ্ঠানে অংশ নিতে অনীহা দেখা দেয়। রোগীরা মানসিক চাপ এবং বিষণ্নতার শিকার হয়। পরিবারের সমর্থন ও সামাজিক সহযোগিতা মানসিক স্বাস্থ্য রক্ষায় অপরিহার্য। চিকিৎসা এবং নিয়মিত রক্ত সঞ্চালন মানসিক চাপ কমাতে সাহায্য করে।
শারীরিক সমস্যা যেমন ক্লান্তি, দুর্বলতা এবং সংক্রমণ মানসিক চাপকে আরও বাড়িয়ে দেয়। তাই থ্যালাসেমিয়ার চিকিৎসার সঙ্গে মানসিক সহায়তা একসাথে থাকা জরুরি। রোগীকে পরিবারের স্নেহ, বন্ধুদের সমর্থন এবং সমাজের সহযোগিতা প্রয়োজন। মানসিক স্বাস্থ্যের যত্ন ছাড়া থ্যালাসেমিয়ার রোগীরা স্বাভাবিক জীবনযাপন করতে অক্ষম হয়।
থ্যালাসেমিয়া কি ভালো হয়?
থ্যালাসেমিয়া একটি দীর্ঘস্থায়ী এবং জেনেটিক রোগ, যা সাধারণত জীবনভর থাকে। বর্তমানে চিকিৎসা থাকলেও এটি পুরোপুরি নিরাময়যোগ্য নয়। অনেক রোগী নিয়মিত চিকিৎসা এবং রক্ত সঞ্চালনের মাধ্যমে তাদের জীবনযাত্রা নিয়ন্ত্রণে রাখতে পারে। রোগটি “ভালো” হওয়া মূলত রোগীর শারীরিক স্বাস্থ্য, চিকিৎসা গ্রহণের নিয়মিততা এবং মানসিক সহায়তার ওপর নির্ভর করে।
শরীরে হিমোগ্লোবিনের ঘাটতি থাকলে ক্লান্তি, দুর্বলতা, শ্বাসকষ্ট এবং অন্যান্য সমস্যাগুলি দেখা দেয়। নিয়মিত চিকিৎসা এবং পর্যাপ্ত রক্ত সঞ্চালনের মাধ্যমে এই সমস্যা অনেকাংশে কমানো যায়। আয়রন কেলেশন থেরাপি ব্যবহার করে শরীরে অতিরিক্ত আয়রন বের করা হয়। এটি দীর্ঘমেয়াদে হৃদপিণ্ড, লিভার এবং কিডনির স্বাস্থ্যের জন্য জরুরি। শিশুরা নিয়মিত চিকিৎসা পেলে শারীরিক বৃদ্ধি প্রায় স্বাভাবিকভাবে হতে পারে।
থ্যালাসেমিয়ার রোগীরা যদি পরিবারের সহযোগিতা, সামাজিক সমর্থন এবং মানসিক সহায়তা পান, তারা সাধারণ জীবনে অংশগ্রহণ করতে সক্ষম হয়। স্কুল, কাজ, সামাজিক অনুষ্ঠান এবং বন্ধুত্বপূর্ণ সম্পর্ক বজায় রাখা সম্ভব হয়। তবে চিকিৎসা এড়িয়ে গেলে রোগের জটিলতা বৃদ্ধি পায়। প্লীহা বা লিভার বড় হওয়া, হৃদপিণ্ডের সমস্যা, সংক্রমণের ঝুঁকি এবং হাড়ের বিকৃতি দেখা দিতে পারে।
বাংলাদেশে থ্যালাসেমিয়ার জন্য বিশেষ যত্ন প্রয়োজন। নিয়মিত ডাক্তারি পরামর্শ, রক্ত পরীক্ষা, পুষ্টিকর খাদ্য এবং মানসিক সহায়তা রোগীর জীবনমান উন্নত করতে সাহায্য করে। রোগীরা সচেতন হলে অনেক জটিলতা এড়াতে পারে। মানসিক চাপ ও হতাশা কমাতে পরিবার এবং বন্ধুদের সমর্থন অপরিহার্য।
শিশুদের ক্ষেত্রে নিয়মিত চিকিৎসা ও স্কুলে অংশগ্রহণের সুযোগ মানসিক এবং সামাজিক উন্নয়নের জন্য গুরুত্বপূর্ণ। প্রাপ্তবয়স্কদের ক্ষেত্রে চাকরি এবং দৈনন্দিন জীবন স্বাভাবিক রাখা সম্ভব। রোগীরা শারীরিক ও মানসিক স্বাস্থ্য বজায় রেখে দীর্ঘস্থায়ী জীবনযাপন করতে পারে। তাই থ্যালাসেমিয়া পুরোপুরি নিরাময়যোগ্য না হলেও নিয়মিত যত্ন এবং চিকিৎসার মাধ্যমে রোগটি নিয়ন্ত্রণযোগ্য এবং জীবনযাপন তুলনামূলকভাবে ভালো করা সম্ভব।
বহুল জিজ্ঞাসিত প্রশ্ন ও উত্তর সমূহ
থ্যালাসেমিয়া রোগের কারণ ও লক্ষণ এই বিষয়ে আপনার মনে বেশ কয়েকটি প্রশ্ন উঁকি দিচ্ছে? তাহলে চলুন জেনে নেই সেই সকল প্রশ্ন ও উত্তরগুলো-
থ্যালাসেমিয়ার জন্য কী ধরনের চিকিৎসা প্রয়োজন?
থ্যালাসেমিয়ার চিকিৎসায় মূলত নিয়মিত রক্ত সঞ্চালন, আয়রন কেলেশন থেরাপি এবং পুষ্টিকর খাদ্য গ্রহণ গুরুত্বপূর্ণ। এছাড়া শিশুর বৃদ্ধি ও হাড়ের বিকৃতি নিয়ন্ত্রণ করতে ডাক্তারি পরামর্শ নিয়মিত নেওয়া প্রয়োজন।
থ্যালাসেমিয়া কি জীবনভর সমস্যার কারণ হয়?
হ্যাঁ, থ্যালাসেমিয়া একটি দীর্ঘস্থায়ী রোগ। তবে নিয়মিত চিকিৎসা, সচেতন জীবনধারা এবং মানসিক সহায়তার মাধ্যমে রোগী সাধারণ জীবনযাপন করতে সক্ষম হয় এবং অনেক জটিলতা এড়ানো যায়।
উপসংহার
থ্যালাসেমিয়া একটি জটিল এবং দীর্ঘস্থায়ী রোগ, যা শিশুর জন্মের সময় থেকেই প্রভাব ফেলে। এটি রক্তের হিমোগ্লোবিন উৎপাদনে সমস্যা তৈরি করে এবং শরীরের সমস্ত অঙ্গপ্রত্যঙ্গকে দুর্বল করে। রোগীর জীবনযাত্রা এবং মানসিক স্বাস্থ্যেও গভীর প্রভাব ফেলে। তবে নিয়মিত চিকিৎসা, রক্ত সঞ্চালন, আয়রন কেলেশন থেরাপি এবং পর্যাপ্ত পুষ্টি গ্রহণের মাধ্যমে রোগের জটিলতা অনেকাংশে কমানো সম্ভব।
শিশুদের ক্ষেত্রে শারীরিক বৃদ্ধি, মানসিক বিকাশ এবং সামাজিক জীবন স্বাভাবিক রাখতে বিশেষ যত্ন প্রয়োজন। প্রাপ্তবয়স্কদের ক্ষেত্রে পেশাগত কার্যক্রম, পরিবার এবং সামাজিক জীবনে অংশগ্রহণ বজায় রাখতে চিকিৎসা অপরিহার্য। পরিবারের সহযোগিতা এবং সামাজিক সহায়তা রোগীর মানসিক স্বাস্থ্য রক্ষা করে।
থ্যালাসেমিয়ার কারণে হাড়ের বিকৃতি, প্লীহা ও লিভার বড় হওয়া, হৃদপিণ্ডের সমস্যা এবং সংক্রমণের ঝুঁকি দেখা দেয়। তবে নিয়মিত চিকিৎসা এবং সচেতনতা রোগীর জীবনমান উন্নত করতে সাহায্য করে। রোগী শারীরিক ও মানসিকভাবে সুস্থ থাকলে দৈনন্দিন জীবনযাপন প্রায় স্বাভাবিক হয়।
বাংলাদেশে রোগী এবং পরিবারকে সচেতন হওয়া দরকার। রোগের আগামি ধাপগুলো চিহ্নিত করে যথাসময়ে চিকিৎসা নেওয়া অত্যন্ত জরুরি। মানসিক সহায়তা, সামাজিক সমর্থন এবং চিকিৎসা একসাথে থাকলে থ্যালাসেমিয়ার রোগীরা দীর্ঘস্থায়ী, সুস্থ এবং সুন্দর জীবনযাপন করতে পারে।







